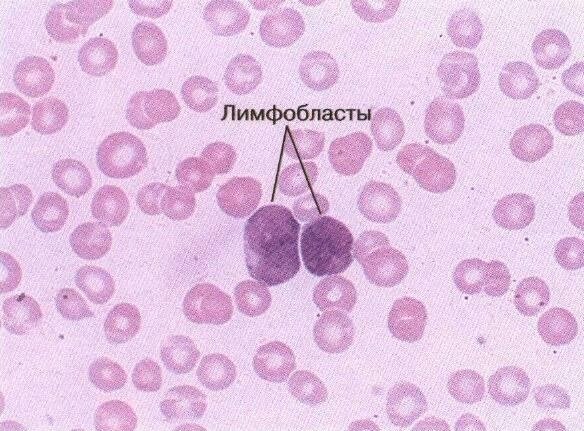
Острый лейкоз характеризуется присутствием в костном мозге и периферической крови бластоцитов

Воспользуйтесь поиском по сайту:
Острый лейкоз
Содержание статьи:
Острый лейкоз – онкологическое заболевание кроветворной системы. Субстрат опухоли при лейкозах составляют бластные клетки.
Все клетки крови происходят из одного источника – стволовых клеток. В норме они созревают, проходя дифференцирование и развиваясь по пути миелопоэза (ведет к образованию эритроцитов, лейкоцитов, тромбоцитов) или лимфопоэза (ведет к образованию лимфоцитов). При лейкозах же стволовая клетка крови мутирует в костном мозге на ранних этапах дифференцирования и в дальнейшем не может завершить развитие по одному из физиологических путей. Она начинает неконтролируемо делиться и образует опухоль. Со временем патологические незрелые клетки вытесняют нормальные клетки крови.
Исследование красного костного мозга – самый главный и точный метод диагностики острого лейкоза. Для заболевания характерна специфическая картина – увеличение уровня бластных клеток и угнетение образования эритроцитов.
Синонимы: острая лейкемия, рак крови, белокровие.
Причины и факторы риска
Точные причины возникновения лейкоза не известны, но установлен ряд факторов, способствующих его развитию:
- радиотерапия, радиационное облучение (об этом говорит массивный рост лейкоза на территориях, где проводилось тестирование ядерного оружия или в местах техногенных ядерных катастроф);
- вирусные инфекции, угнетающие иммунную систему (Т-лимфотропный вирус, вирус Эпштейна – Барр и др.);
- влияние агрессивных химических соединений и некоторых лекарственных средств;
- табакокурение;
- стрессы, депрессия;
- наследственная предрасположенность (если один из членов семьи страдает от острой формы лейкоза, риск проявления его у близких увеличивается);
- неблагоприятная экологическая обстановка.
Формы заболевания
В зависимости от скорости размножения злокачественных клеток лейкоз классифицируют на острый и хронический. В отличие от других заболеваний острый и хронический являются разными типами лейкоза и не переходят один в другой (т. е. хронический лейкоз не продолжение острого, а отдельный вид заболевания).
Острые лейкозы подразделяют в соответствии с видом раковых клеток на две большие группы: лимфобластные и нелимфобластные (миелоидные), которые дальше делятся на подгруппы.
Лимфобластный лейкоз в первую очередь поражает костный мозг, далее – лимфатические узлы, вилочковую железу, лимфатические узлы и селезенку.
В зависимости от того, какие клетки-предшественники лимфопоэза преобладают, острый лимфобластный лейкоз может иметь следующие формы:
- пре-В-форма – преобладают предшественники B-лимфобластов;
- В-форма – преобладают B-лимфобласты;
- пре-Т-форма – преобладают предшественники Т-лимфобластов;
- Т-форма – преобладают Т-лимфобласты.
Средняя продолжительность лечения при остром лейкозе составляет два года.
При нелимфобластном лейкозе прогноз более благоприятен, чем при лимфобластном. Злокачественные клетки так же сначала поражают костный мозг, и только на поздних стадиях затрагивают селезенку, печень и лимфоузлы. Нередко при данной форме лейкоза страдает и слизистая оболочка желудочно-кишечного тракта, что приводит к серьезным осложнениям вплоть до язвенных поражений.
Острые нелимфобластные или, как их еще называют, миелоидные лейкозы, подразделяются на следующие формы:
- острый миелобластный лейкоз – характерно появление большого количества предшественников гранулоцитов;
- острый монобластный и острый миеломонобластный лейкозы – в основе лежит активное размножение монобластов;
- острый эритробластный лейкоз – характеризуется повышением уровня эритробластов;
- острый мегакариобластный лейкоз – развивается вследствие активного размножения предшественников тромбоцитов (мегакариоцитов).
В отдельную группу выделяются острые недифференцированные лейкозы.
Стадии заболевания
Клиническим проявлениям предшествует первичный (латентный) период. В этом периоде лейкоз, как правило, протекает незаметно для пациента, не имея выраженных симптомов. Первичный период может длиться от нескольких месяцев до нескольких лет. На протяжении этого времени первая переродившаяся клетка размножается до такого объема, которое вызывает угнетение нормального кроветворения.
С появлением первых клинических проявлений заболевание переходит в начальную стадию. Симптомы ее не отличаются специфичностью. На этой стадии исследование костного мозга более информативно, чем анализ крови, обнаруживается повышенный уровень бластных клеток.
На стадии развернутых клинических проявлений появляются истинные симптомы заболевания, которые обусловлены угнетением кроветворения и появлением в периферической крови большого количества незрелых клеток.
Современное лечение химиопрепаратами обеспечивает 5 лет без рецидива у детей в 50–80% случаев. При отсутствии рецидива в течение 7 лет есть шанс на полное излечение.
В этой стадии выделяют следующие варианты течения заболевания:
- пациент не предъявляет жалоб, выраженная симптоматика отсутствует, но в анализе крови обнаруживаются признаки лейкоза;
- у пациента отмечается значительное ухудшение самочувствия, но нет выраженных изменений со стороны периферической крови;
- и симптоматика, и картина крови говорят об остром лейкозе.
Ремиссия (период стихания обострения) может быть полной и неполной. О полной ремиссии можно говорить при отсутствии симптомов острого лейкоза и бластных клеток в крови. Уровень бластных клеток в костном мозге не должен превышать 5%.
При неполной же ремиссии происходит временное стихание симптоматики, однако уровень бластных клеток в костном мозге не уменьшается.
Рецидивы острого лейкоза могут возникать как в костном мозге, как и вне его.
Последней, самой тяжелой стадией течения острого лейкоза является терминальная. Она характеризуется большим количеством незрелых лейкоцитов в периферической крови и сопровождается угнетением функций всех жизненно важных органов. На этой стадии заболевание практически неизлечимо и чаще всего заканчивается летальным исходом.
Симптомы острого лейкоза
Симптомы острого лейкоза проявляются анемическим, геморрагическим, инфекционно-токсическим и лимфопролиферативным синдромами. Каждая из форм заболевания имеет свои особенности.
Острый миелобластный лейкоз
Для острого миелобластного лейкоза характерно небольшое увеличение селезенки, поражение внутренних органов тела и повышенная температура тела.
При развитии лейкозного пневмонита очаг воспаления находится в легких, главные симптомы в таком случае – кашель, одышка и повышение температуры тела. У четверти больных с миелобластным лейкозом наблюдают лейкозный менингит с жаром, головной болью и ознобами.
По статистике, безрецидивная выживаемость после трансплантации костного мозга составляет от 29 до 67% в зависимости от вида лейкоза и некоторых других факторов.
На поздней стадии может развиться почечная недостаточность, вплоть до полной задержки мочи. В терминальной стадии заболевания на коже появляются розовые или светло-коричневые образования – лейкемиды (лейкозы кожи), а печень становится более плотной и увеличивается. Если лейкоз затронул органы желудочно-кишечного тракта, наблюдаются сильные абдоминальные боли, вздутие живота и жидкий стул. Могут образоваться язвы.
Острый лимфобластный лейкоз
Для лимфобластной формы острого лейкоза характерно значительное увеличение селезенки и лимфатических узлов. Увеличенные лимфоузлы становятся заметными в надключичной области, сначала с одной стороны, а потом с обеих. Лимфатические узлы уплотняются, не вызывают болезненных ощущений, но могут затронуть соседние органы.
При увеличении лимфоузлов, расположенных в районе легких, появляется кашель и одышка. Поражение мезентериальных лимфатических узлов в брюшной полости может вызывать сильные боли в животе. У женщин могут наблюдаться уплотнение и боли в яичниках, чаще с одной стороны.
При остром эритромиелобластном лейкозе на первое место выходит анемический синдром, который характеризуется снижением гемоглобина и эритроцитов в крови, а также повышенной утомляемостью, бледностью и слабостью.
Особенности протекания острого лейкоза у детей
У детей острые лейкозы составляют 50% от всех злокачественных болезней, и именно они являются наиболее частой причиной детской смертности.
 encrypted-tbn0.gstatic.com
encrypted-tbn0.gstatic.comПрогноз острого лейкоза у детей зависит от нескольких факторов:
- возраст ребенка на момент возникновения лейкоза (наиболее благоприятный у детей от двух до десяти лет);
- стадия заболевания на момент диагностики;
- форма лейкоза;
- пол ребенка (у девочек прогноз более благоприятный).
У детей прогноз при остром лейкозе более благоприятен, чем у взрослых, что подтверждается данными статистики.
Если ребенок не получит специфического лечения, вероятен летальный исход. Современное лечение химиопрепаратами обеспечивает 5 лет без рецидива у детей в 50–80% случаев. При отсутствии рецидива в течение 7 лет есть шанс на полное излечение.
Для предупреждения рецидива детям с острым лейкозом нежелательно проводить физиотерапевтические процедуры, подвергаться интенсивной инсоляции и менять климатические условия проживания.
Читайте также:Польза и вред сдачи крови: 12 заблуждений о донорстве
Диагностика острого лейкоза
Нередко острый лейкоз обнаруживается по результатам анализа крови при обращении пациента по другому поводу – в лейкоцитарной формуле обнаруживается так называемый бластный криз, или лейкоцитарный провал (отсутствие промежуточных форм клеток). Также наблюдаются изменения и в периферической крови: в большинстве случаев у пациентов с острым лейкозом развивается анемия с резким показателем снижения эритроцитов и гемоглобина. Отмечается падение уровня тромбоцитов.
Что касается лейкоцитов, то здесь может наблюдаться два варианта: как лейкопения (снижение уровня лейкоцитов в периферической крови), так и лейкоцитоз, (повышение уровня этих клеток). Как правило, в крови обнаруживаются и патологические незрелые клетки, однако они могут отсутствовать, их отсутствие не может являться поводом для исключения диагноза острого лейкоза. Лейкоз, при котором в крови обнаруживается большое количество бластных клеток, называется лейкемическим, а лейкоз с отсутствием бластных клеток – алейкемическим.
Исследование красного костного мозга – самый главный и точный метод диагностики острого лейкоза. Для заболевания характерна специфическая картина – увеличение уровня бластных клеток и угнетение образования эритроцитов.
В отличие от других заболеваний острый и хронический являются разными типами лейкоза и не переходят один в другой (т. е. хронический лейкоз не продолжение острого, а отдельный вид заболевания).
Другим важным диагностическим методом является трепанобиопсия кости. Срезы костей направляют на биопсию, которая позволяет выявить бластную гиперплазию красного костного мозга и таким образом подтвердить заболевание.
Лечение острого лейкоза
Лечение острого лейкоза зависит от нескольких критериев: от возраста пациента, его состояния, стадии заболевания. План лечения составляется для каждого пациента индивидуально.
В основном заболевание лечится при помощи химиотерапии. При ее неэффективности прибегают к трансплантации костного мозга.
Химиотерапия состоит из двух последовательных шагов:
- этап индукции ремиссии – добиваются уменьшения бластных клеток в крови;
- этап консолидации – необходим для уничтожения оставшихся раковых клеток.
Далее может последовать реиндукция первого шага.
Средняя продолжительность лечения при остром лейкозе составляет два года.
Трансплантация костного мозга обеспечивает больному здоровые стволовые клетки. Трансплантация состоит из нескольких этапов.
- Поиск совместимого донора, забор костного мозга.
- Подготовка пациента. В ходе подготовки проводят иммуносупрессивную терапию. Ее цель – уничтожение лейкозных клеток и подавление защитных сил организма, чтобы риск отторжения трансплантата был минимальным.
- Собственно трансплантация. Процедура напоминает переливание крови.
- Приживление костного мозга.
Чтобы трансплантированный костный мозг полностью прижился и стал выполнять все свои функции, требуется около года.
По статистике, безрецидивная выживаемость после трансплантации костного мозга составляет от 29 до 67% в зависимости от вида лейкоза и некоторых других факторов.
Возможные осложнения и последствия
Острый лейкоз может спровоцировать разрастание раковых опухолей в местах скопления лимфоузлов, геморрагический синдром и анемию. Осложнения острого лейкоза бывают опасными и часто заканчиваются летальным исходом.
Прогноз при остром лейкозе
У детей прогноз при остром лейкозе более благоприятен, чем у взрослых, что подтверждается данными статистики.
При нелимфобластном лейкозе прогноз более благоприятен, чем при лимфобластном.
При лимфобластном лейкозе пятилетняя выживаемость у детей составляет 65–85%, у взрослых – от 20 до 40%.
Острый миелобластный лейкоз более опасен, показатель пятилетней выживаемости у пациентов младшего возраста составляет 40–60%, а у взрослых – всего 20%.
Профилактика
Для острого лейкоза не существует специфической профилактики. Необходимо регулярно посещать врача и своевременно проходить все необходимые обследования в случае появления подозрительных симптомов.
Источники
- Волкова М. А. Острые лейкозы. 2008. Клиническая онкогематология. Фундаментальные исследования и клиническая практика;
- Баранова О. Ю. Острые лейкозы. 2012. Клиническая онкогематология. Фундаментальные исследования и клиническая практика;
- Бондаренко С. Н., Семенова Е. В. Острые лейкозы. 2012. Клиническая онкогематология. Фундаментальные исследования и клиническая практика;
- Паровичникова Е. Н. Острые лейкозы. 2011. Клиническая онкогематология. Фундаментальные исследования и клиническая практика;
- Волкова М. А. Острые лейкозы. 2009. Клиническая онкогематология. Фундаментальные исследования и клиническая практика;
- Захаров О. Д. Острые лейкозы. 2008. Клиническая онкогематология. Фундаментальные исследования и клиническая практика.
Видео с YouTube по теме статьи:
Об авторе

Диплом по специальности «Педиатрия», Санкт-Петербургский государственный педиатрический медицинский университет
Интернатура по специальности «Эндокринология», Кировская государственная медицинская академия
Информация является обобщенной и предоставляется в ознакомительных целях. При первых признаках болезни обратитесь к врачу. Самолечение опасно для здоровья!
Многие наркотики изначально продвигались на рынке, как лекарства. Героин, например, изначально был выведен на рынок как лекарство от детского кашля. А кокаин рекомендовался врачами в качестве анестезии и как средство повышающее выносливость.